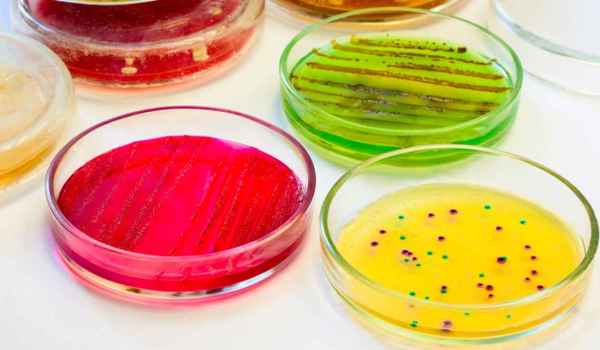
Curso de Enfermedades infecciosas causadas por hongos

Curso de Enfermedades infecciosas causadas por hongos
Datos generales
Los hongos, por sus características, son los grandes desconocidos de la microbiología clínica. Concretamente, están constituidos por células con una estructura eucariota con el material genético distribuido en un núcleo y con una membrana celular rígida. Además, tienen una gran capacidad de adaptación, por lo que pueden desarrollarse sobre cualquier medio o superficie y, precisamente, esa incapacidad para crear sus propios nutrientes es la causa de que puedan ser beneficiosos o perjudiciales para la salud.
Este programa formativo contiene material teórico y práctico que hace hincapié en aquellos hongos que son más frecuentes y que más morbimortalidad causan en la actualidad. Así, el alumno aprenderá los tipos de hongos que existen y su morfología, así como el proceso de recogida, transporte y procesamiento de muestras para el estudio de infecciones fúngicas.
Metodología Innovadora
En Formación Alcalá, apostamos por las técnicas y herramientas educativas más actuales para que tu experiencia de aprendizaje sea realmente dinámica, motivadora y efectiva.
Flexibilidad y Acceso 24/7
Ponemos a tu alcance todos los materiales y recursos online para que puedas aprender a tu ritmo y desde donde quieras, en cualquier momento del día.
Equipo docente especializado
Nuestro equipo docente está formado por profesionales apasionados y comprometidos que te acompañarán durante todo el proceso formativo, siempre dispuestos a ayudarte.
Titulación con validez en todo el territorio nacional
Tu esfuerzo merece reconocimiento: da un paso más en tu formación con una titulación que impulse tu carrera.
Certificación
Universidad San Jorge
El Curso de Enfermedades infecciosas causadas por hongos está certificado con 100 Horas, 4 Créditos ECTS por la prestigiosa Universidad San Jorge. Todo el personal que realice un Curso, Máster o Experto Universitario de Formación Alcalá avalado por la Universidad San Jorge (USJ), recibirá, en caso de realizar un Máster o un Experto Universitario un diploma en Créditos ECTS y horas, ya que los estudiantes de estos títulos propios deben ser Diplomados, Graduados o Licenciados, si el programa de formación se trata de un Curso Universitario.
La USJ bajo ningún concepto expedirá el título universitario correspondiente al programa formativo si el alumno/a no ha finalizado con éxito la evaluación correspondiente y no ha transcurrido el tiempo mínimo desde la matrícula. Una vez transcurrido el tiempo mínimo que exige la dicha universidad y finalice la edición, Formación Alcalá procederá a tramitar el expediente académico a la Universidad San Jorge para que esta expida los diplomas, los cuales serán enviados a cada uno de los alumnos por Formación Alcalá, este trámite suele tardar unos cuatro meses para los Cursos Universitarios y de seis a nueve meses cuando se trata de Máster o Expertos Universitarios.

Todos los Cursos, Másteres y Expertos Universitarios acreditados por esta Universidad son válidos en todas las bolsas y oposiciones a excepción de Murcia. Para una información más amplia y concisa, consulte con su convocatoria o su bolsa.
Modelo de Diploma de la Universidad San Jorge
Todos los alumnos españoles al finalizar sus formaciones, recibirían un diploma como el siguiente:


¿Tienes alguna duda?
Llámanos o escríbenos por WhatsApp, estamos aquí para ayudarte.

Plan de estudios
Requisitos de acceso
- Copia del DNI, TIE o Pasaporte.
Plazo inscripción
La inscripción en este curso online / a distancia permanecerá abierta durante todo el año.
Duración
El discente tendrá un tiempo máximo de 6 meses para su finalización.
Evaluación
La evaluación se realiza online y estará compuesta:
- 59 Preguntas opción múltiple A/B/C.
El alumno debe finalizar el curso y hacerlo con aprovechamiento de, al menos, un 50% en cada actividad que deben realizar.
Este programa formativo online / a distancia está dirigido a todo aquel personal de:
- Licenciados/as o graduados/as en farmacia.
- Licenciados/as o graduados/as en medicina.
- Técnicos superior.
- Diplomados/as o graduados/as en enfermería.
- Tomar contacto con las características de los hongos, grandes desconocidos de la microbiología clínica.
- Analizar la clasificación y morfología de los distintos hongos.
- Estudiar el proceso de recogida, transporte y procesamiento de muestras para el estudio de infecciones fúngicas, así como los métodos de detección e identificación de los hongos.
- Profundizar en las infecciones fúngicas más frecuentes y que causan mas morbi-mortalidad en la actualidad.
- Habilidades críticas y autocríticas.
- Resolución de problemas.
- Gestión y manejo de información interdisciplinarios.
- Comprensión de diversidad y multiculturalidad.
- Diseño y gestión de proyectos.
- Capacidad de trabajar de manera autónoma.
- Capacidad de aplicar los conocimientos adquiridos al trabajo profesional del personal sanitario desde una perspectiva globalizadora.
- Capacidad para observar, analizar y documentar procesos educativos.
- Trabajo en equipo.
Temario
- Introducción.
- Clasificación y morfología.
- Procedimientos de laboratorio.
- Introducción y conceptos generales.
- Medios utilizados para el aislamiento primario.
- Pretratamiento, cultivo y procesamiento de muestras:
- Muestras de sangre.
- Líquidos estériles.
- Exudados, muestras purulentas y drenajes.
- Muestras del tracto respiratorio.
- Secreciones vaginales.
- Muestras oculares.
- Uñas, piel, pelo.
- Médula ósea.
- Orina.
- Tejido.
- Incubación.
- Introducción.
- Examen microscópico directo.
- Detección de antígenos:
- Criptococosis.
- Histoplasmosis.
- Candidiasis.
- Aspergilosis.
- Detección química:
- Metabolitos específicos de hongos.
- Componentes estructurales.
- Detección de ácidos nucleicos.
- Introducción.
- Descripción de los agentes etiológicos:
- Trichophyton spp.
- Microsporum spp.
- Epidermophyton floccosum.
- Clínica.
- Mecanismos de transmisión y contagio.
- Diagnóstico:
- Recogida y transporte de muestras.
- Examen microscópico.
- Medios de cultivo.
- Identificación.
- Micosis superficiales:
- Tiña o Pityriasis versicolor.
- Tiña negra.
- Piedra negra.
- Piedra blanca.
- Mucormycosis:
- Patogenia.
- Clínica:
- Mucormicosis rinocerebral.
- Mucormicosis pulmonar.
- Mucormicosis gastrointestinal.
- Mucormicosis cutánea.
- Mucormicosis diseminada.
- Mucormicosis en SIDA.
- Mucormicosis en enfermos hematológicos.
- Mucormicosis en receptores de trasplante de órgano sólido.
- Diagnóstico:
- Recogida y transporte de muestras.
- Examen microscópico directo.
- Histopatología.
- Cultivo.
- Tratamiento.
- Introducción.
- Características de hongos dimórficos:
- Histoplasma capsulatum.
- Blastomyces dermatitidis.
- Coccidioides inmitis.
- Paracoccidioides brasiliensis.
- Micosis sistémicas debidas a hongos dimórficos:
- Patogenia.
- Epidemiología y manifestaciones clínicas:
- Histoplamosis.
- Blastomicosis.
- Coccidioidomicosis.
- Paracoccidioidomicosis.
- Recogida, almacenamiento y transporte de muestras.
- Diagnóstico:
- Examen directo.
- Cultivo.
- Diagnóstico antigénico.
- Sondas de ácidos nucleicos.
- Tratamiento.
- Introducción.
- Significación clínica.
- Recogida, transporte y procesamiento de muestras.
- Identificación:
- Sporothrix spp.
- Alternaria spp.
- Exophiala spp.
- Bipolaris spp.
- Scedosporium spp.
- Diagnóstico serológico y molecular.
- Tratamiento: sensibilidad a antifúngicos.
- Definición y epidemiología.
- Transmisión y sintomatología general.
- Recogida y examen de las muestras:
- Características de los gránulos en tejidos.
- Descripción de los principales agentes etiológicos:
- Pseudallescheria boydii.
- Madurella mycetomatis.
- Acremonium falciforme.
- Madurella grisea.
- Exophiala jeanselmei.
- Tratamiento.
- Características generales de las levaduras.
- Toma de muestras, transporte y almacenamiento y procesamiento.
- Examen directo.
- Identificación:
- Características macroscópicas.
- Características microscópicas.
- Estudios morfológicos.
- Test del tubo germinal.
- Formación de ascosporas.
- Test fenol oxidasa.
- Test de la ureasa.
- Test de asimilación de carbohidratos.
- Test de asimilación de nitratos.
- Test de fermentación de carbohidratos.
- Identificación rápida de levaduras.
- Métodos moleculares.
- Características de las levaduras clínicamente importantes:
- Género Candida.
- Género Cryptococcus.
- Género Malassezia.
- Género Rhodotorula.
- Género Saccharomyces.
- Sensibilidad y resistencia a antifúngicos.
- Introducción.
- Descripción del género pneumocystis.
- Epidemiología.
- Clínica:
- Presentación en niños.
- Presentación en adultos.
- Presentación extrapulmonar.
- Recogida y manipulación de muestras.
- LBA.
- EI:
- Biopsia pulmonar a cielo abierto.
- BTB:
- Aspiración nasofaríngea
- Identificación y diagnóstico:
- Microscopia.
- Detección mediante PCR y otras técnicas.
- Tratamiento.
- Introducción.
- Género aspergillus:
- Significación clínica.
- Diagnóstico:
- Recogida, transporte, almacenamiento y procesamiento de muestras.
- Examen directo.
- Inmunodiagnóstico y detección de metabolitos.
- Detección de anticuerpos.
- Detección de antígenos.
- Tests cutáneos.
- Técnicas moleculares.
- Otros hongos moniliáceos:
- Penicillium spp.
- Fusarium spp.
- Introducción.
- Antifúngicos disponibles para uso tópico.
- Antifúngicos disponibles para uso sistémico:
- Polienos:
- Mecanismo de acción.
- Espectro de actividad.
- Farmacología.
- Uso clínico.
- Efectos adversos.
- Azoles:
- Mecanismo de acción.
- Imidazoles.
- Ketoconazol:
- Espectro de actividad.
- Farmacología.
- Uso clínico.
- Efectos secundarios.
- Triazoles.
- Fluconazol:
- Espectro de actividad.
- Farmacología.
- Uso clínico.
- Efectos secundarios.
- Itraconazol:
- Espectro de actividad.
- Farmacología.
- Uso clínico.
- Efectos secundarios.
- Mecanismos de resistencia de los azoles.
- Polienos:
- Antimetabolitos: flucitosina:
- Mecanismo de acción.
- Espectro de actividad.
- Farmacología.
- Eficacia clínica.
- Efectos secundarios.
- Mecanismos de resistencia.
- Alilaminas:
- Mecanismo de acción.
- Espectro de actividad.
- Farmacología.
- Uso clínico.
- Efectos secundarios.
- Equinocandinas:
- Mecanismo de acción.
- Espectro de actividad.
- Farmacología.
- Uso clínico.
- Efectos secundarios.
- Griseofulvina.
- Mecanismo de acción.
- Espectro de actividad.
- Farmacología.
- Uso clínico.
- Efectos secundarios.
- Nuevos tratamientos antifúngicos.
- Introducción.
- Métodos estandarizados para levaduras:
- Microdilución.
- Macrodilución.
- Métodos alternativos en caldo para levaduras:
- Colorimetría.
- Espectrofotometría.
- Test punto de corte.
- Citometría de flujo.
- Métodos alternativos en agar para levaduras:
- E-test.
- Test de tamaño de colonias.
- Método de dilución en agar semisólido.
- Métodos estandarizados para hongos filamentosos:
- Microdilución.
- Macrodilución.
- Métodos alternativos para hongos filamentosos en caldo:
- Cambios morfológicos.
- Métodos colorimétricos.
- Métodos alternativos para hongos filamentosos en agar:
- Dilución en agar.
- E-test.
- Método de difusión en disco.
Metodología
Tu formación a distancia se adapta a ti gracias a nuestra plataforma online. Podrás acceder al contenido, descargar materiales y realizar tu formación desde cualquier lugar, sin barreras.
Así hablan quienes confían en Formación Alcalá
Miles de profesionales del sector sanitario, educativo y empresarial marcan la diferencia en su carrera gracias a nuestra formación. No lo decimos nosotros: descubre en sus palabras cómo la experiencia en Formación Alcalá transforma su día a día y potencia sus logros profesionales.



Me pareció ideal. Rápido de entender.